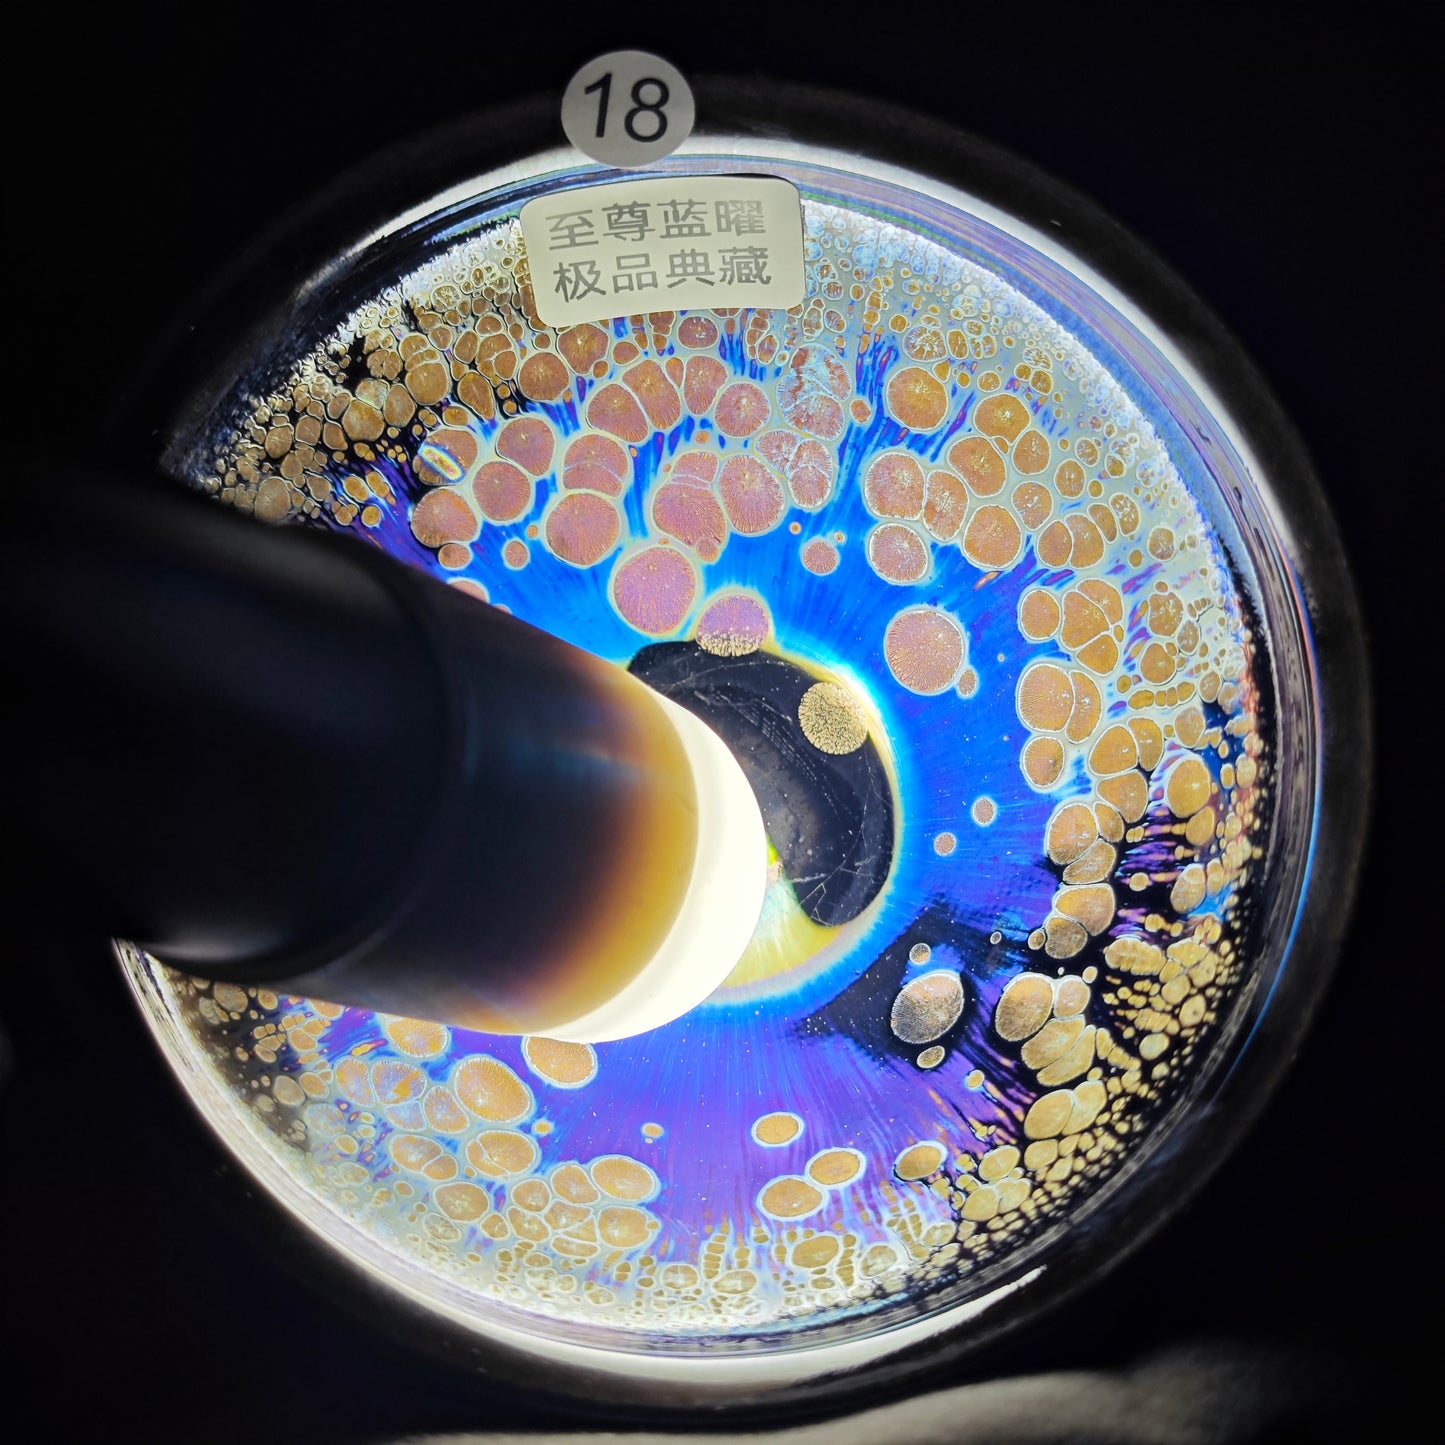

2025.6.17-Master Liu zi-long
2025.6.17-Master Liu zi-long
Couldn't load pickup availability
 View full details
View full details

No.1 teacup Livestream Series
-
天目開窯 2025-09-15
Regular price From $0.00 USDRegular priceUnit price / per -
(John pick)9.5
Regular price From $49.00 USDRegular priceUnit price / per -
(John pick)08.29
Regular price From $99.00 USDRegular priceUnit price / per$0.00 USDSale price From $99.00 USD -
(John pick)08.28
Regular price $75.00 USDRegular priceUnit price / per -
(John pick)08.26
Regular price From $20.00 USDRegular priceUnit price / per -
(John pick)08.25
Regular price From $139.00 USDRegular priceUnit price / per -
 Sold out
Sold out(John pick)08.23
Regular price $0.00 USDRegular priceUnit price / per -
(John pick)08.22
Regular price From $0.00 USDRegular priceUnit price / per -
2025.08.18 Master Li
Regular price $105.00 USDRegular priceUnit price / per -
(Michael pick)08.03
Regular price From $0.00 USDRegular priceUnit price / per -
2025.07.25 Master you
Regular price From $70.00 USDRegular priceUnit price / per -
2025.7.24 Master Ji
Regular price From $79.00 USDRegular priceUnit price / per -
2025.7.23 Master zhang
Regular price From $79.00 USDRegular priceUnit price / per -
2025.7.22-Master zhang
Regular price From $45.00 USDRegular priceUnit price / per -
2025.7.21-Master wang
Regular price From $50.00 USDRegular priceUnit price / per -
2025.7.20 Master huang
Regular price From $139.00 USDRegular priceUnit price / per -
2025.7.19 Master cheng
Regular price From $29.00 USDRegular priceUnit price / per -
2025-7-17 Master Qian
Regular price From $40.00 USDRegular priceUnit price / per -
2025-7-16-Master Li
Regular price From $0.00 USDRegular priceUnit price / per -
2025.7.11 Master zhi
Regular price From $40.00 USDRegular priceUnit price / per -
2025.7.10 master Lin
Regular price From $50.00 USDRegular priceUnit price / per -
2025.7.9-Master Fan
Regular price From $35.00 USDRegular priceUnit price / per -
2025.7.8-Master Ji
Regular price From $199.00 USDRegular priceUnit price / per -
2025.7.7-Master Ji
Regular price From $79.00 USDRegular priceUnit price / per

1. Clay selection. Jian Zhan's glaze and clay need to have a high iron content. Other kilns in the Song Dynasty tried to imitate Jian Zhan. Still, they usually could not succeed for the minerals in their geographic location could hardly meet the standards of making a Jian Zhan.
2. Crushing. Place the prepared clay and glaze in a machine for pulverization
3. Washing and sieve. The thickness of the clay or glaze should be moderate. After sieving, the clay needs to be put into the slurry tank, while the glaze needs to be placed in the glaze pool.
4. Chen Fu, which is a ceramic terminology, refers to placing the clay in a room away from sunlight and air, keeping a certain temperature and humidity, and storing it for a while.
5. Knead the clay. This process is aimed to further remove the air and impurities in the clay, make the mud dense, uniform humidity, and facilitate forming, meanwhile, it also prevents the clay from drying and cracking during post-production.
6. Shaping, is usually divided into hand shaping and machine shaping.
7. Modification. The traditional shape of Jian Zhan is mainly a shallow circle foot, and the base part and the “inner ring ” of the foot need to be modified by a knife.
8. Kiln the unglazed Jian Zhan. This process can increase the mechanical strength of the clay, and also remove a part of the cracked and fragile Jian Zhan in advance.
9. Blend glaze. The glaze formula of the ancient method is to use natural iron ore glaze and plant ash. These two simple substances can compose a beautiful glaze, which looks incredible, but the craft of making Jian Zhan is to use the simplest materials to create the most mysterious crystals.
10. Glazed. One of the big features of Jian Zhan's crafting is the half-glazed. Ancient people would specially design a glaze line to facilitate the control of the glaze range. Glazing also needs very skillful technique, ensure the glaze is moderate. If thin, the room for the growth of the crystal is too small to produce delicate works; if too thick, the glaze may easily stick to the bottom.
11. Put into the kiln. There is usually a need to place a layer of alumina powder on the bottom to avoid sticking.
12. Kiln and fire the Jian Zhan. The kiln is the most important process of making Jian Zhan. If the time, degree, and frequency of reduction are not well mastered, the desired glaze color will not be successfully created. After being put into the kiln, the master must concentrate on controlling the degree of reduction and not leave it for a long time.
13. Finishing kiln. After the kiln, due to various restrictions on the making process, each kiln will inevitably produce defective products, which must be disposed of on-site. Products that pass the quality inspection can be sold.
You may also like
-
Master fan da fu
Regular price $415.00 USDRegular priceUnit price / per -
Master ji guo jun
Regular price $2,999.00 USDRegular priceUnit price / per -
Master zhou yu jian Order tea
Regular price $159.00 USDRegular priceUnit price / per -
Master jiang hong yi representative works
Regular price $499.00 USDRegular priceUnit price / per -
Master luo xi Mosquito repellent incense cup Three
Regular price $75.00 USDRegular priceUnit price / per -
Master ji guo ping vase
Regular price $1,999.00 USDRegular priceUnit price / per -
Master Liu yun hua Four seasons lights in spring, summer, autumn and winter
Regular price $365.00 USDRegular priceUnit price / per -
Master Ren feng carve gaiwan
Regular price $399.00 USDRegular priceUnit price / per -
Master Liu tang shen
Regular price $4,000.00 USDRegular priceUnit price / per -
Master Liu tang shen The magical brilliance of golden light
Regular price $1,069.00 USDRegular priceUnit price / per -
Master Liu tang shen
Regular price $359.00 USDRegular priceUnit price / per -
Master wu xiao qing 11cm heavy-calibre
Regular price $189.00 USDRegular priceUnit price / per -
Master fan ze feng gold and jade fill the hall --dark-red enameled pottery
Regular price $549.00 USDRegular priceUnit price / per -
Master fan ze feng Old mud material dark-red enameled pottery 120cc
Regular price $269.00 USDRegular priceUnit price / per -
Master Wang jing min Hand carved stone teapot Only one.
Regular price $5,999.00 USDRegular priceUnit price / per -
Master You chao Sancai gaiwan
Regular price $159.00 USDRegular priceUnit price / per -
Master You chao Exquisite sculpture
Regular price $1,279.00 USDRegular priceUnit price / per -
Master Lian Hong da Chinese francolin Order tea
Regular price $150.00 USDRegular priceUnit price / per -
Master Lian Hong da Chinese francolin
Regular price $150.00 USDRegular priceUnit price / per -
Master Xie ai hua gaiwan
Regular price $180.00 USDRegular priceUnit price / per -
Master Xie ai hua Pinch fair mug.
Regular price $110.00 USDRegular priceUnit price / per -
Master Zhi jing Sancai Gai Bowl and fair mug
Regular price $251.00 USDRegular priceUnit price / per -
Master Zhi jing turn the tide in the Year of the Ox
Regular price $2,480.00 USDRegular priceUnit price / per -
Master Zhi jing Set of seven
Regular price $119.00 USDRegular priceUnit price / per -
Master zhi jing handwork Big vase
Regular price $499.00 USDRegular priceUnit price / per
About No.1 Teacup
At No.1 teacup, we preserve the centuries-old legacy of Chinese ceramic mastery, blending time-honored techniques with modern design to create exquisite porcelain that elevates everyday life with artistry, quality, and cultural essence.











































































